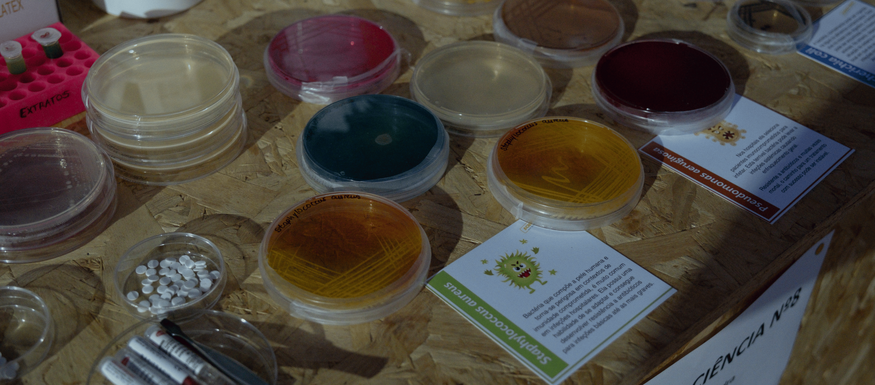

área de conteúdos (não partilhada)
Noite Europeia dos Investigadores uniu várias gerações em Armamar
área partilhada
área partilhada
Conteúdo atualizado em21 de maio de 2025às 12:14